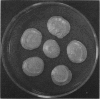
1001

Full text
PDF




Images in this article
Selected References
These references are in PubMed. This may not be the complete list of references from this article.
- AJELLO L. Occurrence of Cryptococcus neoformans in soils. Am J Hyg. 1958 Jan;67(1):72–77. doi: 10.1093/oxfordjournals.aje.a119921. [DOI] [PubMed] [Google Scholar]
- APPELBAUM E., SHTOKALKO S. Cryptococcus meningitis arrested with amphotericin B. Ann Intern Med. 1957 Aug;47(2):346–351. doi: 10.7326/0003-4819-47-2-346. [DOI] [PubMed] [Google Scholar]
- CARTON C. A. Treatment of central nervous system cryptococcosis: a review and report of four cases treated with actidione. Ann Intern Med. 1952 Jul;37(1):123–154. doi: 10.7326/0003-4819-37-1-123. [DOI] [PubMed] [Google Scholar]
- EMMONS C. W. Isolation of Cryptococcus neoformans from soil. J Bacteriol. 1951 Dec;62(6):685–690. doi: 10.1128/jb.62.6.685-690.1951. [DOI] [PMC free article] [PubMed] [Google Scholar]
- HOLMES S. J., HAWKS G. H. Torulosis of the central nervous system. Can Med Assoc J. 1953 Feb;68(2):143–146. [PMC free article] [PubMed] [Google Scholar]
- KAO C. J., SCHWARZ J. The isolation of Cryptococcus neoformans from pigeon nests; with remarks on the identification of virulent cryptococci. Am J Clin Pathol. 1957 Jun;27(6):652–663. doi: 10.1093/ajcp/27.6.652. [DOI] [PubMed] [Google Scholar]
- RING E. D., WILLIAMS T. H. Torulosis. Can Med Assoc J. 1952 Oct;67(4):360–361. [PMC free article] [PubMed] [Google Scholar]
- SMITH D. L., FISCHER J. B., BARNUM D. A. Generalized cryptocococcus neoformans infection in a dog. Can Med Assoc J. 1955 Jan 1;72(1):18–20. [PMC free article] [PubMed] [Google Scholar]
- Saddington R. S. YEAST INFECTION IN MAN: With a report of a case. Can Med Assoc J. 1932 May;26(5):544–546. [PMC free article] [PubMed] [Google Scholar]